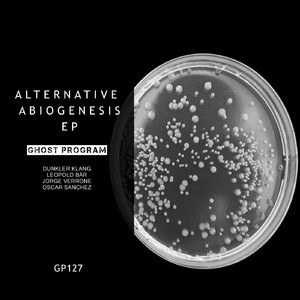
Richelieu

时间走了
Richelieu

cold
Richelieu

Richelieu
Cleshe

全世界在我身后
Richelieu

Richelieu
Royal 22nd Regiment Band

四季信笺
Richelieu

北极星
Richelieu

半间不界
Richelieu

cold
Richelieu

On My Way
Richelieu

雨落后的天空
Richelieu

听风 7320版
Richelieu

Richelieu
Vittorio Matteucci, Giò Di Tonno, GRAZIANO GALATONE

Richelieu (From "I tre moschettieri")
Giò Di Tonno, Vittorio Matteucci, GRAZIANO GALATONE

Richelieu
Historock

Richelieu
Triodesign

Richelieu
Thomas Fersen

Richelieu
Marie-Andrée Ostiguy, Michel Donato, Daniel Zanella, Paul Fortin, Jean-Marie Benoit, Jacques Beaudoin, Eugene Huzaruk, Geneviève Beaudry, Daniel Godin, Vanessa Huzaruk, Alexandra Kadlecova, Monique Poitras, Gratiel Robitaille, Sherry Steinberg, Margot Aldrich, Christiane Lampron, Carole Bogenez, Christine Giguère, Sylvie Lambert

Listen to My Voice Focusing on Living
Richelieu

Down Fantasy Thoughts
Richelieu

Regardless of Humanity
Richelieu

Travel Pill Far Away
Richelieu

Richelieu
CAL

Richelieu
Andre Pettipas and the Giants
Richelieu
OSCAR SANCHEZ

Sur le tapis, étendu
Richelieu

Camion
Richelieu

Chaise de plastique
Richelieu

Quand t'arrives pas
Richelieu

Même si
Richelieu